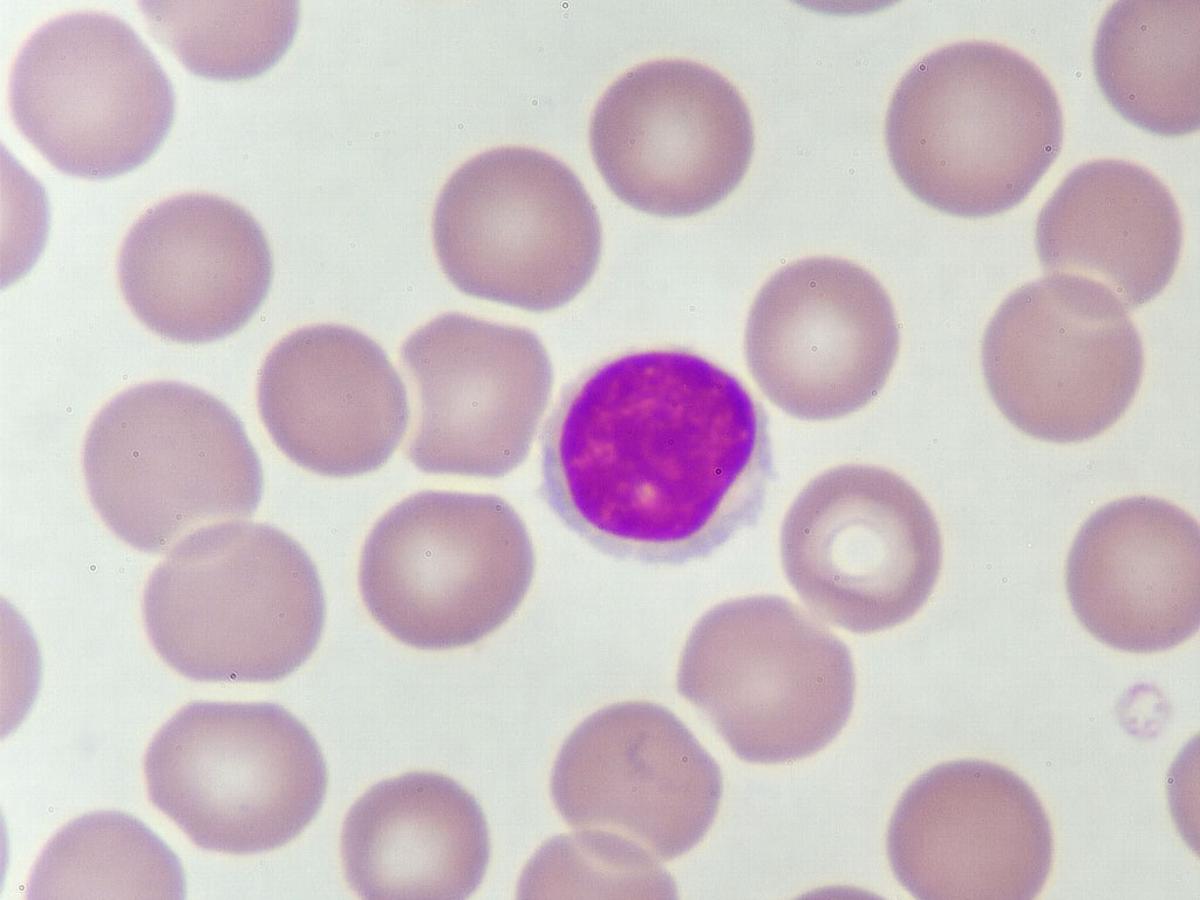

一个“好”癌症
作为学术医学中心的执业医师,医学博士约翰·海斯利普(John haylip)教授学生和同行医生血癌之间的区别。每当他介绍慢性淋巴细胞白血病(CLL)的话题时,他都会听到一个常见的副歌。
“人们会说,‘啊,CLL……这是一种好的癌症,对吗?’”现在担任艾伯维医疗总监的海斯利普说。“或者,‘你是死于疾病,而不是死于疾病。’”
Hayslip将向他的同事解释CLL,虽然不迅速致命,但确实是即使在重复的剩余后也倾向于重新传递的严重疾病 - 随着每次后续复发而变得更加挑战。
缺少的缩写
治疗CLL的复杂性最好通过另一首缩写:MRD拼写。这代表了最少的残留疾病,是在白血细胞中发现的一定数量的白血病细胞定义的客观测量。